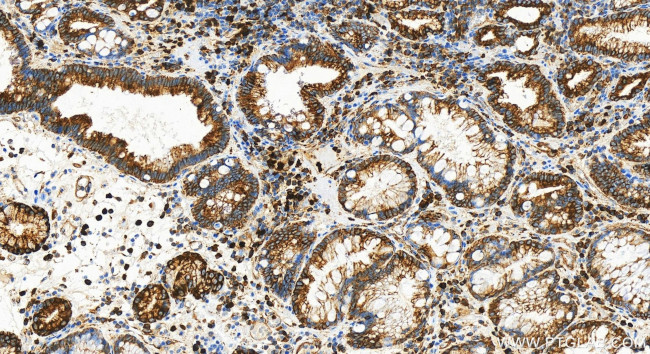
Drebrin Antibody in Immunohistochemistry (Paraffin) (IHC (P))

Search
Proteintech
Drebrin Recombinant Rabbit Monoclonal Antibody (240599G12)
{{$productOrderCtrl.translations['antibody.pdp.commerceCard.promotion.promotions']}}
{{$productOrderCtrl.translations['antibody.pdp.commerceCard.promotion.viewpromo']}}
{{$productOrderCtrl.translations['antibody.pdp.commerceCard.promotion.promocode']}}: {{promo.promoCode}} {{promo.promoTitle}} {{promo.promoDescription}}. {{$productOrderCtrl.translations['antibody.pdp.commerceCard.promotion.learnmore']}}
产品信息
83591-2-RR
种属反应
宿主/亚型
Expression System
分类
类型
克隆号
抗原
偶联物
形式
浓度
纯化类型
保存液
内含物
保存条件
运输条件
产品详细信息
Immunogen sequence: ASSVEDIDAG AIGQRLSNGL ARLSSPVLHR LRLREDENAE PVGTTYQKTD AAVEMKRINR EQFWEQAKKE EELRKEEERK KALDERLRFE QERMEQERQE QEERERRYRE REQQIEEHRR KQQTLEAEEA KRRLKEQSIF GDHRDEEEET HMKKSESEVE EAAAIIAQRP DNPREFFKQQ ERVAS
靶标信息
The protein encoded by this gene is a cytoplasmic actin-binding protein thought to play a role in the process of neuronal growth. It is a member of the drebrin family of proteins that are developmentally regulated in the brain. A decrease in the amount of this protein in the brain has been implicated as a possible contributing factor in the pathogenesis of memory disturbance in Alzheimer's disease. At least two alternative splice variants encoding different protein isoforms have been described for this gene.
仅用于科研。不用于诊断过程。未经明确授权不得转售。
篇参考文献 (0)
生物信息学
蛋白别名: Developmentally-regulated brain protein; DKFZp434D064; Drebrin; drebrin A; drebrin E; drebrin E2; drebrin-1
基因别名: D0S117E; DBN1; Drba
UniProt ID: (Human) Q16643, (Rat) Q07266, (Mouse) Q9QXS6
Entrez Gene ID: (Human) 1627, (Rat) 81653, (Mouse) 56320